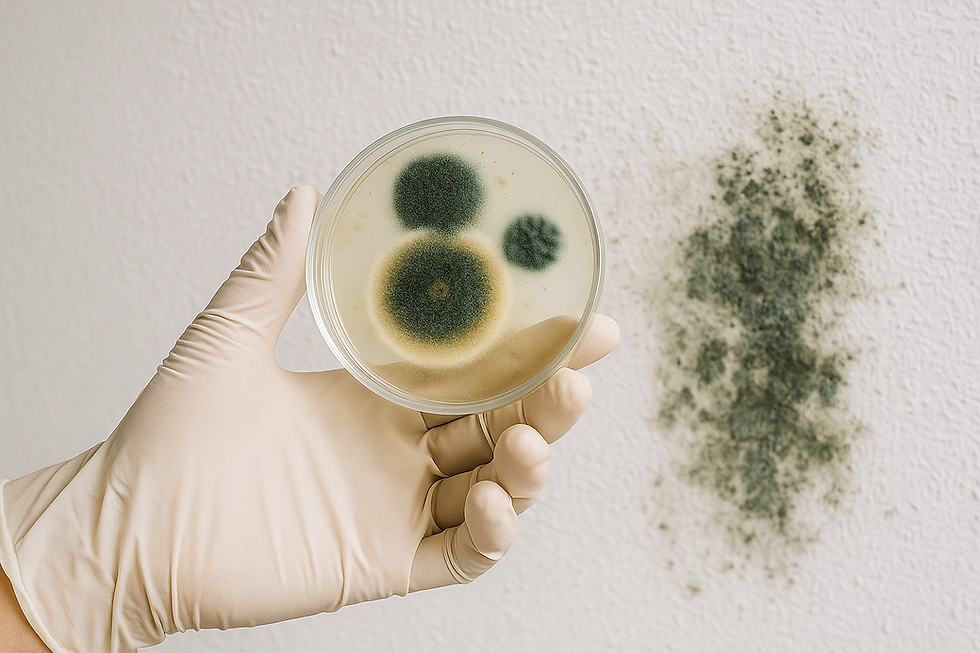
Schimmelsporen werden vom Schimmelscout aufgedeckt. Ein Service des Sachverständigenbüro Walter aus Nachrodt-Niblingwerde

Schimmelscout

Ihr Schimmelscout erkennt die Ursachen, beurteilt das Ausmaß und gibt Sanierungsempfehlungen!
Schimmelscout - Ein Service des Sachverständigenbüro Walter
.png)
Sauerland/Ruhrgebiet, Rheinland, Rhein/Düssel
AP: Roy Walter - Wir sind für Sie da!
Schimmel entdeckt?
Zuerst analysieren, dann sanieren!
Schimmel kann unser Immunsystem angreifen und gleichzeitig unser Zuhause! Darum ist es wichtig, die Ursachen schnell zu finden und erst danach den Befall nachhaltig zu entfernen. Deshalb unser Rat!
Bevor Sie handeln, lassen Sie uns prüfen, analysieren und bewerten.
Das Sachverständigenbüro Walter sorgt für Klarheit – bevor der Schaden größer wird.
Schimmel erkennen.........verstehen.........richtig handeln!

Was ist Schimmel?
Pilze, und damit auch Schimmel, sind eine eigene Gattung, also weder Pflanze noch Tier. Sie brauchen kein Licht, und nur ca. 1% an Sauerstoff, den z. B. Menschen benötigen. Sie finden bei ausreichender Feuchte in den meisten Baustoffen gute Lebensbedingungen. Da sie zunächst verdeckt entstehen spricht man bei Schimmelpilzschäden von sogenannten „okkulten“ Schäden. Das macht es häufig recht aufwändig und für den Laien i. d. R. schwierig, Schimmelpilze als Verursacher von Schäden oder gesundheitlichen Problemen zu identifizieren. Zur Fortpflanzung bilden sie Sporen, die nur wenige Mikrometer groß sind und durch die Luft fortbewegt werden.
Sporen sind häufig die Hauptverursacher von gesundheitlich negativen Wirkungen

Wie erkenne ich Schimmel?
Schimmel in Wohn- und Aufenthaltsräumen ist nicht immer auf den ersten Blick erkennbar. Oft entsteht der Befall zunächst unauffällig – verdeckt und versteckt u. a. hinter Möbeln, Tapeten oder in Wand- und Dachkonstruktionen. Er kann punktuell oder rasenartig auftreten. Je früher Schimmel entdeckt und sachgerecht begutachtet wird, desto geringer ist in der Regel der Sanierungsaufwand.
Typische Anzeichen für Schimmelbefall:
-
Verfärbungen an Wänden, Decken oder Fugen
-
Muffiger, erdiger Geruch
-
Feuchte Stellen mit u. a. schwarzen Punkten
-
unspezifische gesundheitliche Beschwerden
Verdeckter Schimmel – die unsichtbare Gefahr!
.png)
Was tun bei Schimmel?
Schimmel in Wohnungen oder im Gebäuden ist nicht bloß ein optisches Problem – es ist ein ernstzunehmendes Warnsignal für z. B. zu hohe Feuchtigkeit und möglicher Bauschäden. Wer Schimmel bei sich entdeckt, sollte möglichst schnell handeln, aber nicht auf eigene Faust! Stattdessen zeitnah einen zert. Sachverständigen für Schimmelschäden hinzuziehen.
Das Sachverständigenbüro Walter unterstützt Sie mit Expertenwissen, modernster Messtechnik und Analyseverfahren, um die Ursachen von Schimmelbefall sachgerecht zu ermitteln und somit eine nachhaltige und kosteneffiziente Sanierung zu ermöglichen.
Schimmel immer zuerst sachverständig analysieren lassen – bevor Sie handeln!
Fach- und sachgerechte Begutachtung und Sanierung bei Schimmelbefall!
.png)

Eine erfolgreiche Schimmelbeseitigung beginnt nicht mit einer Reinigung – sondern mit einer fundierten Ursachenanalyse. Ohne einer Analyse der genauen Ursache wird Schimmel immer wieder auftreten. Deshalb ist eine fach- und sachgerechte Begutachtung durch einen unabhängigen und zertifizierten Sachverständigen wie das Sachverständigenbüro Walter elementar wichtig. Wir als Schimmelscout erkennen für Sie die Ursachen, beurteilen das Ausmaß und geben fundierte Sanierungsempfehlungen.
Unsere Büros in NRW - wir sind aber auch gern deutschlandweit für Sie tätig!
Büro Sauerland/Ruhrgebiet
AP: Roy Walter
Wiesenstr. 1, 58769 Nachrodt-Wiblingwerde
Büro Rheinland
AP: Walter Menzel
Goebenstr. 24, 52351 Düren
Büro Rhein/Düssel
AP: Roy Walter
Kleinhülsen 43, 40721 Hilden
Weitere Service- und Dienstleistungen des Sachverständigenbüro Walter:
Sachverständigenbüro Walter - geprüfte und zertifizierte Bauwerksdiagnostiker und Sachverständige für Wasser- und Feuchteschäden, Schimmel, Gebäudedichte, Wärme, Lüftung, Sachkunde Asbest. Besuchen Sie gerne unsere Hauptwebseite! Auch hierfür stehen wir Ihnen deutschlandweit zur Verfügung und Seite.
Ihr Asbestscout - ein Service des Sachverständigenbüro Walter. Hier finden Sie alle Informationen rund um das Thema Asbest. Vor ASI-Arbeiten (Abriss, Sanierung, Instandhaltung) muss zwingend auf Asbest untersucht werden (bei Gebäuden, die vor 1995 gebaut wurden). Schauen Sie dazu auf unserer Webseite vorbei.
.png)


